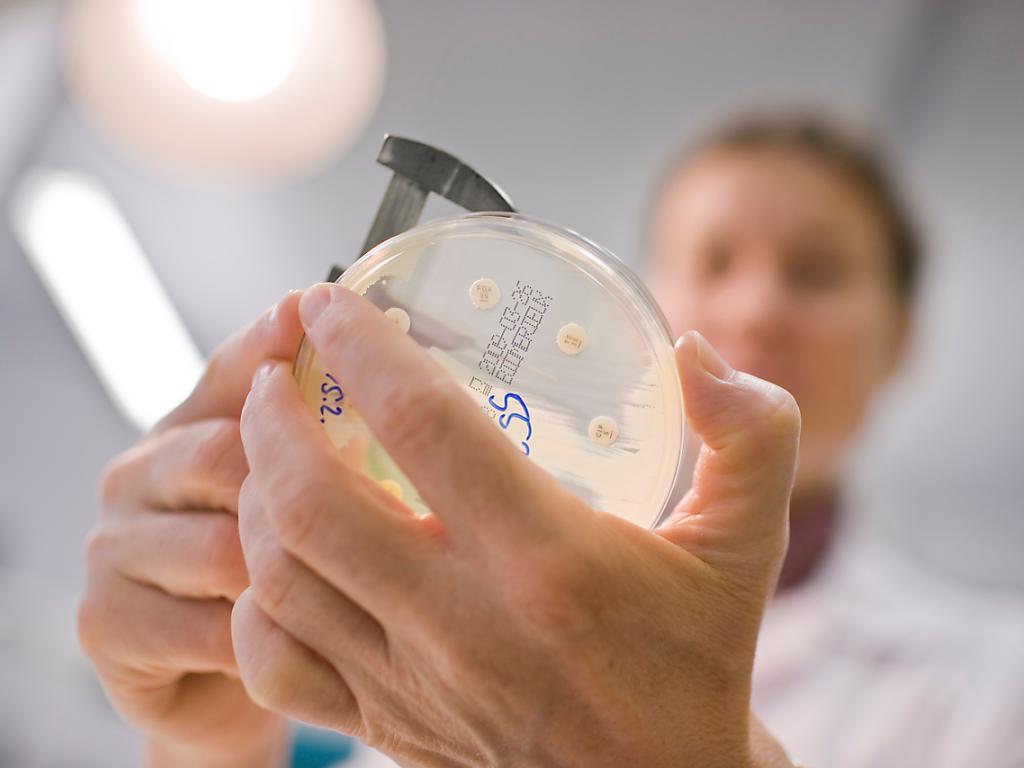

Fondo nazionale svizzero, quasi 3000 nuovi progetti
(Keystone-ATS) Nel 2017 il Fondo nazionale svizzero (FNS) ha sostenuto 2971 nuovi progetti, che per essere approvati hanno dovuto superare un “processo di selezione severo”.
Lo indica lo stesso FNS in una nota nella quale precisa che in totale i programmi di ricerca in corso sono 5800 ai quale lavorano 16’000 ricercatori.
Lo scorso anno, i fondi investiti dal FNS hanno superato il miliardo di franchi, pari a una media di 350’000 franchi per progetto. Di regola la durata dei singoli programmi di ricerca è di quattro anni.























